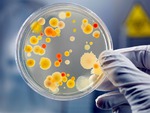
.         .

Шлаки в организме
Материал из Википедии — свободной энциклопедии

«Шла́ки» — распространённая в альтернативной медицине концепция, согласно которой в организме человека постепенно накапливаются некие вредные вещества, которые следует периодически удалять с помощью специальных методик «очистки организма».

Среди методик очищения присутствуют: диеты, голодание, клизмы, виброгимнастика.
Также пропагандируются диеты, которые должны свести к минимуму образование «шлаков» в организме, например: вегетарианство, сыроедение, раздельное питание.

Критика
Концепция шлаков скептически воспринимается множеством специалистов. В основном её противники указывают на отсутствие корректных доказательств существования шлаков (в том смысле, который вкладывается в это понятие сторонниками теорий о необходимости «очистки») как таковых. Нормальный, здоровый организм не накапливает вредных веществ, в то время как сторонники «теорий очищения» и продавцы средств «для очистки организма» просто постулируют существование шлаков, не утруждаясь доказательствами. Указывается также на вполне возможный вред конкретных средств «очистки от шлаков», представляющих собой, преимущественно, различные комбинации диуретиков и слабительных — их постоянное применение может приводить к нарушению работы ЖКТ, почек и других внутренних органов.
ИНФОРМАЦИЯ ВЗЯТА ИЗ ДРУГОГО ИСТОЧНИКА

ЧТО ТАКОЕ ШЛАКИ ОРГАНИЗМА
Все необходимые вещества для жизнедеятельности организма поступают по двум системам: дыхательной и пищеварительной. Конечные продукты обмена белков, жиров, углеводов выводятся из организма по четырем системам: дыхательной ( CO2 и другие газообразные вещества ), мочевыделительной, пищеварительной системами и кожей. Выведение метаболитов клеточного обмена, как и их образование, идет в непрерывном режиме. Чем интенсивнее работают клетки, тем больше образуется конечных продуктов обмена. Нередко эти конечные продукты в популярной литературе называются "шлаками организма". Если мы посмотрим в толковом словаре С. И. Ожегова значение слова шлаки, то это твердый остаток, образующийся после выплавки металла из руды, а также от сжигания угля. По аналогии с организмом человека, это продукт производственной деятельности ( метаболизма в организме ) балласт, от которого необходимо избавиться. Хотя выражение "шлаки организма" не научное слово, но оно прижилось и в медицинской практике и нередко это выражение можно встретить и в научных статьях. Шлаки в первую очередь накапливаются в клетках, межклеточном пространстве. Не выведенные шлаки накапливаются в соединительной ткани, в жировой и костной тканях, в мышцах и органах ( печень, почки, легкие, кишечник и другие ). По мере очищения организма "складированные шлаки" так же выводятся из организма.

ОТКУДА БЕРУТЬСЯ ШЛАКИ ОРГАНИЗМА
Вещества, из которых образуются шлаки в организме человека, имеют экзогенное ( внутреннее- метаболиты клеток ) и эндогенное ( внешнее ) происхождение. К эндогенным веществам относятся все вредные и токсические вещества, попадающие в организм человека через органы дыхания и пищеварения, через кожу и слизистые оболочки. Они могут находиться в воздухе, воде, пище, и во всем том, что нас окружает, с чем мы соприкасаемся. Это окислы и соли тяжелых металлов, нитраты и нитриты, пестициды, химические стимуляторы, красители и консерванты, антибиотики, лекарства, радионуклиды. Сюда относятся и физические факторы, нарушающие процессы метаболизма: воздействие электромагнитного поля, вибрация, шум, световое воздействие ( УФ и другие ).
Накопившиеся продукты обмена клеток и токсические вещества оказывают вредное действие на организм, приводят к дисбалансу физиологических функций, развитию различных заболеваний.

ПРИЗНАКИ ЗАШЛАКОВАННОСТИ ОРГАНИЗМА
Первыми признаками зашлакованности организма являются: усталость, быстрая утомляемость, раздражительность, нередко головная боль. В последующем при нарастании зашлакованности появляется аллергическая реакция, повышенная температура, поражения слизистых ( ринит, конъюктивит ) и кожи ( изменения цвета, сухость, воспаление сальных желез и т.д. ). В дальнейшем, если не удается вывести шлаки, развивается поражение органов ( гастрит, колит, язвенная болезнь, стенокардия, инфаркт миокарда и другие заболевания вплоть до злокачественных опухолей ).
Природа наделила человека уникальной системой самозащиты. Поэтому уже при появлении первых признаков зашлаковки исчезает аппетит, хочется только пить, физического и психологического покоя, что способствует выделительным системам удалить шлаки.
Однако самый лучший путь очищения организма от шлаков является недопущение их образования, т.е. самоограничение, самосовершенствование, самоконтроль. Но как же можно отказаться от сигареты, алкоголя, крепкого чая, кофе, обильного ужина в компании, чревоугодия и других излишеств. Тогда вольно или невольно придется заниматься очищением организма от шлаков.

МЕТОДЫ ОЧИЩЕНИЯ ОРГАНИЗМА ОТ ШЛАКОВ
Методов очищения организма от шлаков очень много. Необходимо помнить, что в выделительной системе организма существует координирующая и регуляторная связь, которая при нарушении функции одной системы ведет к изменению активности другой системы. Например, при заболевании почек, уменьшается выведение азотистых соединений с мочой, увеличивается их выделение через желудочно- кишечный тракт и кожу. При избыточном выведении жидкости через кожу, потовыделение при высокой температуре или физической нагрузке, снижается объем мочи, выделяемой почками.
Поэтому, выбирая методы очищения, последовательность их проведения, нужно руководствоваться функциональной важностью системы и степенью ее загрязненности.
На первом этапе очищение организма от шлаков следует начинать с желудка, кишечника, печени и легких.
На втором этапе проводится чистка почек, крови, лимфы, сосудов, кожи.
На третьем этапе осуществляется очищение суставов и соединительной ткани.
После чистки кишечника,запоры мучали,а до этого все нормально было.
Но хотелось как лучше!
Я для себя выписал 3 важных слова " САМООГРАНИЧЕНИЕ, САМОСОВЕРШЕНСТВОВАНИЕ И САМОКОНТРОЛЬ"
Сейчас очень жалею о той своей увлеченности очистками, так как те проблемы с ЖКТ, которые я имею сейчас родом как раз оттуда. Так что это всё у меня в прошлом, опыт большой и сказать есть что. Сейчас я никому это не посоветую делать самостоятельно. Да и вообще верю в мудрость нашего организма и самоочищение. Учитывая нашу экологию, нам всегда будет хватать вредностей в воде, воздухе, пище. Но если помочь организму и сбалансировать питание, убрав по-максимуму вредное и не полезное, тогда не надо будет форсировать процесс осамоочищения всякими сомнительными методиками. И уж поверьте у многих методов есть такие побочки, о которых авторы даже не заикаются. Желаю всем здоровья и разумного к нему отношения!
Галина ХОЛМОГОРОВА, кандидат медицинских наук, ведущий научный сотрудник ГНИЦ профилактической медицины Минздрава РФ:
- Такого понятия - «шлаки» в медицине просто не существует. Есть метаболиты, есть азотистые соединения, которые выводятся организмом. Человеческий организм - не коврик, его в чистку не сдашь. Можно наладить правильный образ жизни, можно вылечить различные заболевания - например, восстановить нарушенный обмен веществ. Очистить его нельзя. Очищение нам предлагают различные шарлатаны, «психотерапевты», «потомственные ясновидящие» - мало ли что они советуют и мало ли как они калечат людей! Такие «специалисты» не отвечают за последствия.
Возьмем, к примеру, голодание: диетологи во всем мире категорически против него как метода нефизиологичного. Очищать кишечник самопроизвольно - тоже совсем не полезно, клизму следует делать только по назначению врача. Клизмы отнюдь не безопасны для организма, они вымывают микрофлору кишечника. Очищение на уровне крови - и вовсе лечебная процедура, которая должна выполняться строго по показаниям специалистов соответствующими растворами и лекарствами. Нельзя кидаться на все, что рекламируют, - это просто механизм выкачивания денег из людей.
Ждала,когда,кто-нибудь скажет о заговоре фармацевтических компаний.
пока мои разгрузки редкие.но лучше сделать их регулярными в определённый день
я тоже так считаю
Чисто там где не засоряют!
Организм сам знает, когда и что чистить. Нужно только создать подходящие условия для очищения. А решая за организм можно и навредить здоровью